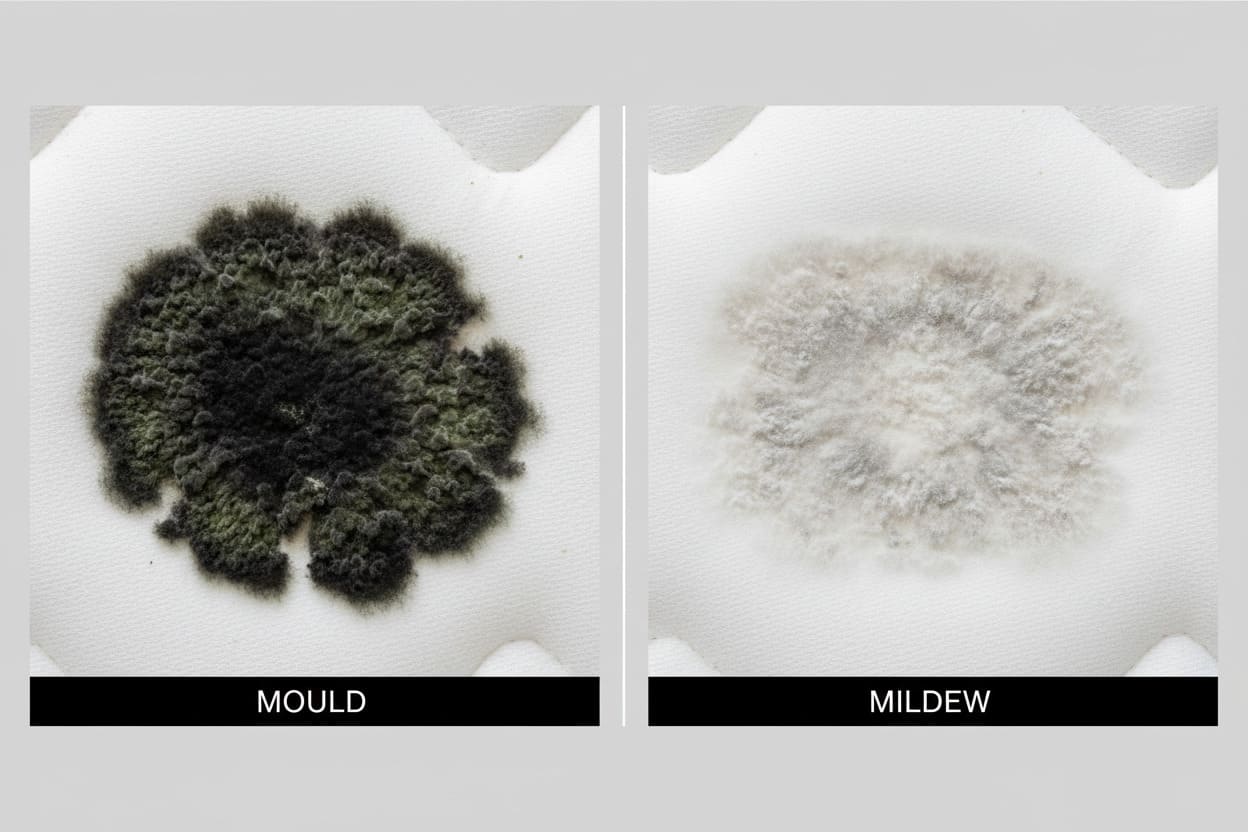
Mould vs. Mildew on Your Mattress

1. Can I sleep on a moldy mattress?
No. Sleeping on a mouldy mattress exposes you to allergens and spores that may trigger coughing, sneezing, headaches, skin irritation, or even respiratory issues. It’s best to clean the mould immediately or replace the mattress if the infestation is severe.
2. Will hydrogen peroxide or rubbing alcohol damage my mattress?
Using either product can potentially harm your mattress depending on how it’s applied. Hydrogen peroxide may lighten fabrics or break down foam if used excessively, while rubbing alcohol can weaken materials over time and is highly flammable. To stay safe, apply only a small amount, patch-test on a hidden spot first, and never mix these cleaners with other chemicals.
3. How long does it take for mould to grow back after cleaning?
If moisture isn’t controlled, mould can return within days. Use a dehumidifier, ensure your room is well-ventilated, and keep the mattress dry to prevent recurring issues.
4. When should I replace a mouldy mattress?
If the mould has spread deeply, has a strong smell that won’t go away, or keeps reappearing after cleaning, it’s safer to replace the mattress — especially for children, elderly people, or anyone with asthma or allergies.
5. Does sunlight kill mould on mattresses?
Direct sunlight helps dry out moisture and can reduce surface mould, but it doesn’t always kill mould deep inside the foam. Use sunlight as part of the cleaning process, not the only solution.